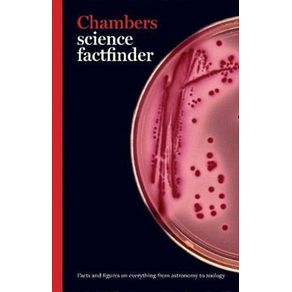
522107_ampliada.jpg 522107_ampliada.jpg

Calcule o frete:
Para envios internacionais, simule o frete no carrinho de compras.
Sinopse
Ficha Técnica
Especificações
| ISBN | 9780550101488 |
|---|---|
| Pré venda | Não |
| Peso | 607g |
| Autor para link | CHAMBERS |
| Livro disponível - pronta entrega | Não |
| Dimensões | 23 x 16 x 1 |
| Tipo item | Livro Importado |
| Número de páginas | 544 |
| Número da edição | 1ª EDIÇÃO - 2006 |
| Código Interno | 522107 |
| Código de barras | 9780550101488 |
| Acabamento | PAPERBACK |
| Autor | CHAMBERS |
| Editora | CHAMBERS |
| Sob encomenda | Não |